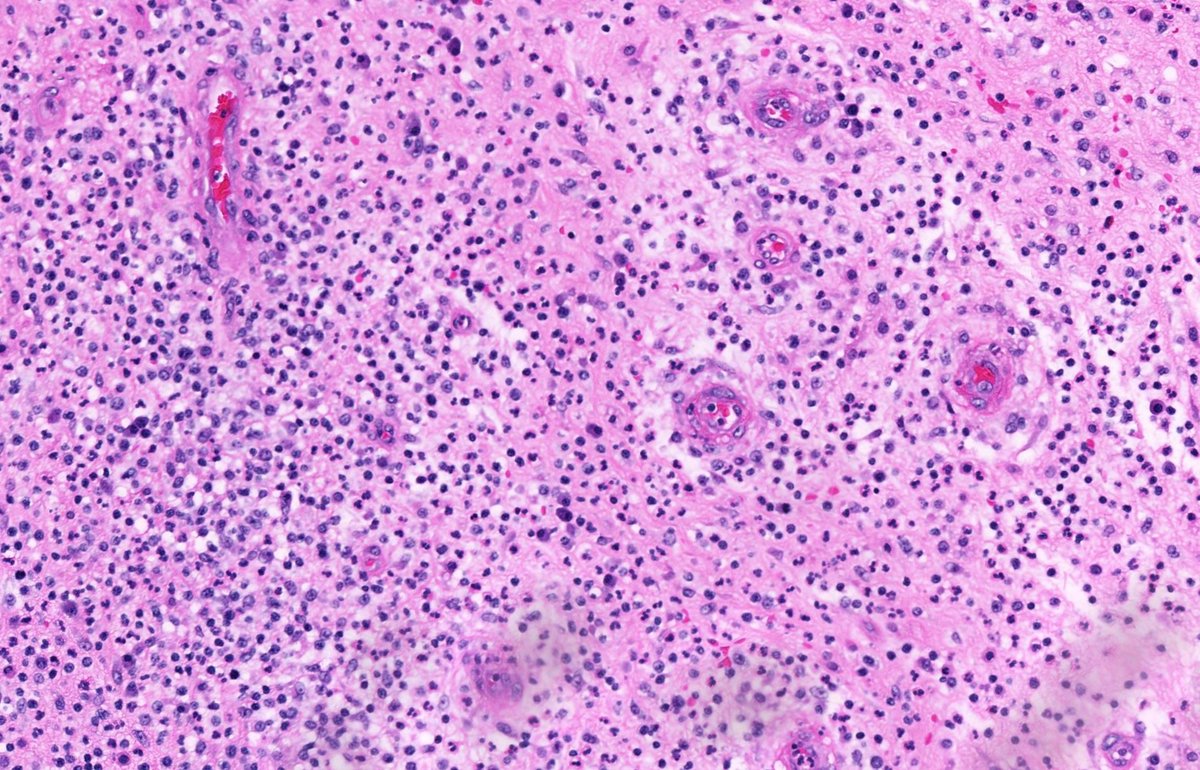

#pathtwitter search results
Hi #PathTwitter👋 I’m Rukiye, a pathologist from Turkey🇹🇷, excited to apply to #PathMatch2026 and pursue my dream of U.S. training 🔬✨ Outside pathology, I enjoy walks and family time with my daughters🥰 Looking forward to connecting with mentors & colleagues! AAMC ID 16779845

Hi #PathTwitter I’m Nada, a 2024 grad and non-US IMG from Egypt 🇪🇬, excited to share I’m applying to #PathMatch2026! Passionate about Surgical & Forensic pathology and capturing the beauty of nature 📸. Looking forward to connect! AAMC ID: 16706480 #pathology #Path2Path

Hi #MedTwitter I'm Rachel, born and raised in 🇧🇷 and excited to be applying to Pathology in the #Match2026! Outside of medicine, I love reading mystery novels and learning new languages. Let's connect! #PathTwitter

Hello #PathTwitter, I am pleased to introduce myself. My name is Jouan Taheri, an Iranian pathologist and research fellow in neuropathology. I am applying to the field of #pathology for #Match2026, building upon a background in anatomical and clinical pathology, with experience…

Hi #PathTwitter 👋 I’m Gelavizh (Gela) Keshtmand, MD, an AP/CP pathologist from Iran, excited to apply for #PathMatch2026 and continue learning in this inspiring field 🔬💜 Grateful for this journey and looking forward to connecting with mentors & colleagues! ✨ #Match2026…

Lupus nephritis case with prominent podocyte cytoplasmic vacuolization on LM with myelin figures revealed by EM. Probably HCQ effect but given its prominence genetic etiologies should be excluded (e.g., Fabry, LMX1B). #renalpath #pathtwitter #nephrology




Lanthanum deposits (from phosphate binders in ESRD) can mimic calcium. Seen 👇 are gray-brown material in GI biopsies in lamina propria. Can travel all the way to the lymph nodes too (PMID: 27515549). Important mimic to recognize! #pathology #pathtwitter #gipath



Hi #PathTwitter I’m Josselyn, an IMG from Ecuador 🇪🇨 excited to apply to #PathMatch2026 🔬🩷 Passionate about cytopathology and mentorship. Outside pathology I enjoy swimming, cooking and reading ✨ Looking forward to connecting with you all! AAMC ID: 16690275 #Match2026


Hello! I’m Sumeyra, a pathologist from 🇹🇷 and a postdoc fellow at the NCI working on prostate cancer. Thrilled to share that I’ve applied for #Match2026 in #Pathology! ✨ Outside the lab, I love biking and spending time with my 🐈 & family. Happy to connect! #PathTwitter #PathX

A startling biopsy. Severe acute TMA in a pt with suspected scleroderma renal crisis. Massive vascular thrombosis, mucoid intimal edema, and early onion skin change associated with severe cortical necrosis. #renalpath #nephrology #pathtwitter




Multinucleated giant cell chomping keratin debris in this squamous cell carcinoma #CytoPath #PathTwitter

70s F, partial nephrectomy. What is your diagnosis? Gross photo in the chat. #PathTwitter @MGBpathology @MGHPathology @PathDocBoston



Vulvar biopsy – HSV infection: 🔬 Histopathology: ulcerated squamous epithelium with prominent inflammatory infiltrate. Acantholytic keratinocytes with multinucleation, nuclear molding, and chromatin margination — the classic “3 M’s” of HSV cytopathic effect. #PathTwitter…




20 yo M. Deep intramuscular calf nodule. SOX-10 +. Loss of SMARCB1 staining. Answer ✅ youtu.be/YrUty8brYHU?si… Digital slides: kikoxp.com/posts/21930 #pathology #pathologists #pathTwitter #dermpath #dermatology #dermatologia #dermtwitter #BSTpath




Red-purple skin nodule on elbow. Diagnosis? Answer ✅ youtu.be/Gbc9RHe5Kko?si… What systemic issues can be associated with this? Digital slide & info: kikoxp.com/posts/24378 #pathology #pathologists #pathTwitter #dermpath #dermatology #dermatologia #dermtwitter




65 yo woman with petechial eruption. Can you guess the patient's medical history? Digital slide: kikoxp.com/posts/8026 Answer ✅ youtu.be/kaBrMU5OsFg?si… #pathology #pathologists #pathTwitter #dermpath #dermatology #dermatologia #dermtwitter




What’s in a name? New meta-analysis of DNA methylation data shows pituitary “adenomas” share more patterns with NETs than with adenomas - backing the PitNET terminology and reshaping how we classify these tumors. #PathTwitter #EndocrinePath link.springer.com/article/10.100…
Skin nodule. Your diagnosis? Answer ✅ youtube.com/watch?v=09feX8… Video 👉🏻 youtube.com/watch?v=E_Sr2c… More pics: kikoxp.com/posts/10372/pu… #pathology #pathologists #pathTwitter #dermpath #dermatology #dermtwitter #dermatologia

What did he drink to turn his skin blue? Fancy name of this condition? Answers ✅ youtu.be/TIqkU4MsD8A?si… #pathology #pathologists #pathTwitter #dermpath #dermatology #dermatologia #dermtwitter

65 yo woman with petechial eruption. Can you guess the patient's medical history? Digital slide: kikoxp.com/posts/8026 Answer ✅ youtu.be/kaBrMU5OsFg?si… #pathology #pathologists #pathTwitter #dermpath #dermatology #dermatologia #dermtwitter




20 yo F. Bilateral groin excisions. Diagnosis? Digital slides: kikoxp.com/posts/8027 Answer ✅ youtu.be/Zy07nO1VuiY?si… #pathology #pathologists #pathTwitter #dermpath #dermatology #dermatologia #dermtwitter

Rare (in my practice) & classic! Only case in my collection. Foot nodule 50 M. Answer ✅ youtu.be/g7PlwuIDs7U?si… Digital slide: kikoxp.com/posts/2338 Clinical pics: kikoxp.com/posts/2341 #Pathology #pathTwitter #dermpath #dermatology #dermatologia #dermtwitter

20 yo M. Deep intramuscular calf nodule. SOX-10 +. Loss of SMARCB1 staining. Answer ✅ youtu.be/YrUty8brYHU?si… Digital slides: kikoxp.com/posts/21930 #pathology #pathologists #pathTwitter #dermpath #dermatology #dermatologia #dermtwitter #BSTpath




Soft tissue nodule. Can you diagnose it from one pic, or is it #TooLowToDiagnose? Answer ✅ youtu.be/EPyakVOCmFs?si… Digital slide: kikoxp.com/posts/51103 #pathology #pathTwitter #dermpath #dermatology #parasitology #dermatologia #dermtwitter

Skin biopsy. A pathology classic. One pic only. Answer ✅ youtu.be/yfs42lmFZfU #pathology #pathologists #pathTwitter #dermpath #dermatology #dermatologia #dermtwitter #usmle

Red-purple skin nodule on elbow. Diagnosis? Answer ✅ youtu.be/Gbc9RHe5Kko?si… What systemic issues can be associated with this? Digital slide & info: kikoxp.com/posts/24378 #pathology #pathologists #pathTwitter #dermpath #dermatology #dermatologia #dermtwitter




80 M scalp. Negative: SOX-10, p40, CK5, desmin, ERG. Your topline diagnosis? Any comment you'd add? Answer ✅ youtube.com/watch?v=mmuehu… Digital slide: kikoxp.com/posts/6840. Sample #pathology report: kikoxp.com/posts/5193 #pathTwitter #dermpath #BSTpath #dermtwitter




What is this bubbly cell? What are the pink dots in the cytoplasm? Diagnosis? Answers ✅ youtu.be/DqLK6ZvNXTU #pathology #pathologists #pathTwitter #dermpath #dermatology #dermatologia #dermtwitter

80 yo man with slowly growing brown patch on cheek. Your diagnosis? Bonus point: what is the WRONG diagnosis? Answer ✅ youtu.be/FQomxOwuIbQ?si… #pathology #pathologists #pathTwitter #dermpath #dermatology #dermatologia #dermtwitter

Adult subQ nodule. Desmin negative. Answer ✅ youtube.com/watch?v=vKPX9e… WSI: kikoxp.com/posts/21101 Other cases: kikoxp.com/posts/8152 & kikoxp.com/posts/18028 Ddx: kikoxp.com/posts/18029 #pathology #pathologists #pathTwitter #dermpath #BSTpath

Synovium excision from infectious septic arthritis. What are these cells in the synovium? Answer ✅ youtu.be/66LHnfxNcBM #pathology #pathologists #pathTwitter #dermpath #dermatology #dermatologia #dermtwitter

Hi #PathTwitter I’m Nada, a 2024 grad and non-US IMG from Egypt 🇪🇬, excited to share I’m applying to #PathMatch2026! Passionate about Surgical & Forensic pathology and capturing the beauty of nature 📸. Looking forward to connect! AAMC ID: 16706480 #pathology #Path2Path

Hi #PathTwitter👋 I’m Rukiye, a pathologist from Turkey🇹🇷, excited to apply to #PathMatch2026 and pursue my dream of U.S. training 🔬✨ Outside pathology, I enjoy walks and family time with my daughters🥰 Looking forward to connecting with mentors & colleagues! AAMC ID 16779845

Hi #MedTwitter I'm Rachel, born and raised in 🇧🇷 and excited to be applying to Pathology in the #Match2026! Outside of medicine, I love reading mystery novels and learning new languages. Let's connect! #PathTwitter

Let’s review cribriform morphology 🍪 in breast pathology this week! Case of Collagenous Spherulosis 🔬 Bland myoepithelial cells baking up collagen balls 🧑🍳✨—looks like adenoid cystic carcinoma or ADH, but it’s a sweet mimic. 😇 #PathX #PathTwitter #breastpath

Hi #PathTwitter I’m Josselyn, an IMG from Ecuador 🇪🇨 excited to apply to #PathMatch2026 🔬🩷 Passionate about cytopathology and mentorship. Outside pathology I enjoy swimming, cooking and reading ✨ Looking forward to connecting with you all! AAMC ID: 16690275 #Match2026


Hello #PathTwitter, I am pleased to introduce myself. My name is Jouan Taheri, an Iranian pathologist and research fellow in neuropathology. I am applying to the field of #pathology for #Match2026, building upon a background in anatomical and clinical pathology, with experience…

Multinucleated giant cell chomping keratin debris in this squamous cell carcinoma #CytoPath #PathTwitter

Hi #PathTwitter 👋 I’m Gelavizh (Gela) Keshtmand, MD, an AP/CP pathologist from Iran, excited to apply for #PathMatch2026 and continue learning in this inspiring field 🔬💜 Grateful for this journey and looking forward to connecting with mentors & colleagues! ✨ #Match2026…

Hello! I’m Sumeyra, a pathologist from 🇹🇷 and a postdoc fellow at the NCI working on prostate cancer. Thrilled to share that I’ve applied for #Match2026 in #Pathology! ✨ Outside the lab, I love biking and spending time with my 🐈 & family. Happy to connect! #PathTwitter #PathX

Lanthanum deposits (from phosphate binders in ESRD) can mimic calcium. Seen 👇 are gray-brown material in GI biopsies in lamina propria. Can travel all the way to the lymph nodes too (PMID: 27515549). Important mimic to recognize! #pathology #pathtwitter #gipath



Female patient undergoing a total hysterectomy and bilateral salpingectomy for "uterine fibroids". Images from the fimbriated end of the fallopian tube. What is your diagnosis? #pathtwitter #pathx #gynpath #gynepath #fallopiantube


70s F, partial nephrectomy. What is your diagnosis? Gross photo in the chat. #PathTwitter @MGBpathology @MGHPathology @PathDocBoston



Lupus nephritis case with prominent podocyte cytoplasmic vacuolization on LM with myelin figures revealed by EM. Probably HCQ effect but given its prominence genetic etiologies should be excluded (e.g., Fabry, LMX1B). #renalpath #pathtwitter #nephrology




Case of Myxoid Fibroadenoma 🪼🔬 The gelatinous cousin of your everyday FA with hypocellular, loose, gooey 🍮 stroma #PathX #PathTwitter #breastpath

Hello #PathTwitter ✨️ I'm Brenda Baltodano, a Peruvian MD 🇵🇪 applying to #PathMatch26. Grateful to share MyERAS application is in and I am ready for the Match ✨️. Outside the scope 🔬: gym, running, and video games 🎮. Let's connect! AAMC ID: 16435959 #Match2026 #pathx

Something went wrong.
Something went wrong.
United States Trends
- 1. Jets 101K posts
- 2. Justin Fields 18.9K posts
- 3. Broncos 42.2K posts
- 4. Aaron Glenn 7,745 posts
- 5. Drake Maye 6,240 posts
- 6. George Pickens 2,522 posts
- 7. London 208K posts
- 8. Sean Payton 3,503 posts
- 9. Tyler Warren 1,879 posts
- 10. Jerry Jeudy N/A
- 11. Garrett Wilson 4,673 posts
- 12. Bo Nix 4,703 posts
- 13. Cooper Rush N/A
- 14. Steelers 27.6K posts
- 15. #Pandu N/A
- 16. Pop Douglas 1,429 posts
- 17. Karty 1,528 posts
- 18. #HardRockBet 3,627 posts
- 19. Tyrod 2,578 posts
- 20. #Patriots 2,406 posts